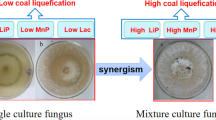

Abstract
The lignin-modifying enzymes (LMEs) play an important role in decomposition of agricultural residues, which contain a certain amount of lignin. In this study, the production of LMEs by three co-cultivated combinations of Phlebia radiata, Dichomitus squalens and Ceriporiopsis subvermispora and the respective monocultures was comparatively investigated. Laccase and manganese peroxidases (MnP) were significantly promoted in the co-culture of P. radiata and D. squalens, and corncob was verified to be beneficial for laccase and MnP production. Moreover, laccase production by co-culture of P. radiata and D. squalens with high ratio of glucose to nitrogen was higher than low ratio under carbon- and nitrogen-meager conditions. New laccase isoenzymes measured by Native-PAGE were stimulated by co-cultured P. radiata with D. squalens or C. subvermispora, respectively, growing in the defined medium containing corncob, but the expression of laccase was greatly restrained by the co-culturing of D. squalens with C. subvermispora. This study showed that the synergistic and depressing effects of co-cultivation of P. radiata, D. squalens and C. subvermispora on LMEs were species specific.
Similar content being viewed by others
Explore related subjects
Discover the latest articles, news and stories from top researchers in related subjects.Avoid common mistakes on your manuscript.
Introduction
Lignin, after cellulose and hemicellulose, is the third most abundant terrestrial biopolymer, which is expected to be used as raw material for the world’s bio-based economy for the production of bioproducts and biofuels. In addition to wood, many agricultural residues, such as wheat straw, corn stalk, corncob and rice stalk, contain a large number of cellulose, hemicelluloses and lignin. The overall worldwide production of cereal straw is estimated to exceed 2,900 million tons each year [1]. However, most of these residues are burned in rural areas of China, thereby losing energy and causing significant pollution. The demand for paper has risen significantly in recent years, which means massive deforestation. Using agricultural residues as raw materials for papermaking can be a good solution. Unfortunately, lignin is a great barrier, because its heterogeneous structure imparts plants with structural rigidity and also serves to protect cellulose and hemicelluloses from degradation [2].
The white-rot fungi are by far the most active ligninolytic organisms, which are able to depolymerize and even mineralize all the components of wood, primarily cellulose, hemicelluloses and lignin [3] with a remarkable ability to decompose the colored, aromatic, heterogeneous and persistent lignin phenylpropanoid units [4]. There are mainly four types of reactions in lignin, including oxidation, demethylation, side-chain oxidation at Cα, and propyl side-chain cleavage between Cα and Cβ [5]. Decomposition of lignin is possible due to the fungal production of particular extracellular lignin-modifying enzymes (LMEs), which are mainly laccase (EC 1.10.3.2), lignin peroxidase (LiP, EC 1.11.1.7), manganese peroxidase (MnP, EC 1.11.1.7) and versatile peroxidase (VP, EC 1.11.1.16) [6]. Also several H2O2-generating enzymes such as aryl alcohol oxidase and glyoxal oxidase are regarded as members of white-rot fungal lignin-degrading machinery [3, 7]. Decomposition of lignin by white-rot fungi and their lignin-degrading enzymes is essential for cycling of organic carbon and releasing more easily degradable plant polysaccharides available for other microbes [8].
Most bioconversions in nature take place by the combination of metabolic pathways from different microorganisms, and many instances show that the co-cultures can lead to a higher enzyme production than monocultures through synergistic interactions [5, 9]. Hu et al. [10] reported that high activities of β-glucosidase, α-cellobiohydrolase, β-galactosidase and laccase were produced by A. oryzae in combination with other fungi, in particular with P. chrysosporium. Laccase was significantly stimulated in the co-culture of P. ostreatus with C. subvermispora, and MnP was stimulated in a co-culture of P. ostreatus with C. subvermispora or P. rivulosus [11]. The study by Chen et al. [12] showed that laccase was significantly stimulated in the co-culture of P. radiata with D. squalens under submerged cultivation, and the improved productions of MnP and LiP were simultaneously observed in the co-culture of P. ostreatus and P. radiata. Moreover, new laccase isozymes were induced in co-cultures of P. ostreatus with T. longibrachiatum [13] and Trametes sp. AH28-2 with Trichoderma sp. [14]. The co-cultures appeared to be advantageous over monocultures because of the potential for synergistic interactions, but the final result mainly depended on the particular microbe’s combination, interactions between species, and the micro-environmental or nutritional conditions in the substrate under colonization [15]. Koroleva et al. [16] reported that the co-cultivation of C. hirsutus (laccase is the predominant enzyme) and C. maxima (MnP the key enzyme) resulted in little or no increases in the production of LMEs.
At present, no reports focus on investigating the effects on lignin-degrading abilities of selectively lignin-degrading white-rot fungi in mixed submerged cultures by different agricultural residues. Lignin degradation mechanisms involve relatively more in several white-rot fungi when cultivated as pure cultures either in liquid cultures or on solid media, but little is known about the biochemistry and enzymology of mixed fungal cultures [11], especially using different agricultural residues for fermentation substrates.
In this study, based on the previous investigation for screening of co-growth examinations, three white-rot fungi, P. radiata, D. squalens and C. subvermispora, which have good co-culturing property, were selected to decompose four agricultural residues, and to investigate the co-cultured production phenotypes of three main LMEs under the submerged co-cultivation. The production phenotypes of laccase and peroxidase by three co-cultivated white-rot fungi in submerged cultures were compared with monocultures, and then the synergistic effect on co-cultivation degrading each raw material was confirmed, which provided more knowledge for lignin degradation mechanism under the co-fungal cultivation.
Materials and methods
Materials and chemicals
All chemicals used as buffers or substrates were commercial products of at least analytical reagent, unless otherwise indicated. ABTS [2,2′-azino-bis(3-ethylbenzthiazoline-6-sulfonic acid) diammonium salt] and veratryl alcohol (VA) were obtained from Sigma Aldrich (St. Louis, MO, USA). Bradford protein quantitative kit was obtained from Tiangen Biotech Co., Ltd. (Beijing, China). NativePAGETM 4–16% Bis–Tris Gels were bought from Invitrogen (California, USA). Ultraviolet–visible absorption spectroscopy was performed on a thermo spectronic photometer (TU-1810) bought from Beijing Purkinje General Instrument Co., Ltd.
Agricultural residues, including corn stalk, corncob, wheat straw and rice stalk, were obtained from Northern Anhui Plains and Zhejiang. Before adding to the culture media, they were dried to constant weight and powdered (60 meshes).
Fungal strains
Phlebia radiata (DSM 5111) and Dichomitus squalens (DSM 9615) were bought from the Deutsche Sammulung von Microorganismen und Zellkulturen (DSMZ), Braunschweig. Ceriporiopsis subvermispora (ACCC 31513) was obtained from Agricultural Culture Collection of China. These fungi were maintained on PDA slants and stored at 4 °C. Before use, the stored fungi were inoculated onto the newly prepared PDA plates and grew for 7 days at 28 °C.
Culture conditions and experimental design
P. radiata, D. squalens, C. subvermispora and the responding co-culturing combinations were inoculated into 250-ml Erlenmeyer flasks containing 30 ml of medium under 140 rpm shaking speed and at 28 °C. The original culture medium (PG medium, modified from Chen et al. [12]) had the following composition (g/L): 1.0 glucose, 0.03 peptone, 0.060 KH2PO4, 0.0001 ZnSO4, 0.04 K2HPO4, 0.00005 FeSO4, 0.005 MnSO4 and 0.050 MgSO4. To the PG medium 2% (w/v) corn stalk, corncob, wheat straw and rice stalk (designated as PGA1, PGA2, PGA3, PGA4 medium, respectively) were added before sterilization. The fungi were pre-grown on potato dextrose agar (PDA) plates for 7 days. Four inoculum plugs (10 × 10 mm) were placed on each 30-ml medium. After inoculation, the cultivation was carried out in a dark chamber under 140 rpm shaking speed at 28 °C. At different times of cultivation, 2 ml of the culture broth was removed and determined for laccase, MnP and LiP, reducing sugar, protein concentration and Native-PAGE as described below. Before determination, the samples were centrifuged at a speed of 12000 r/min for 5 min at 4 °C.
The influences of different C/N ratios on the LME production phenotype were investigated; two different ratios of C/N in the modified PG medium, namely the ratio of 1.0:0.03 (designated as PGA) and 0.1:0.03 (designated as PGB), were designed in this study. Other media compositions did not change, apart from those specifically pointed out.
Assays of LMEs
Laccase and peroxidases activities were both assayed in a 1-ml reaction system using an extracellular medium of the fungal cultures after low temperature centrifugation. Laccase activity was determined by monitoring the oxidation products of 0.4 mM ABTS (molar extinction coefficient 36,000 M−1 cm−1), buffered with 100 mM of sodium tartrate (pH 5.0) at 420 nm [17]. Lignin peroxidase (LiP) was assayed by oxidation of 2.0 mM veratryl alcohol to veratraldehyde (molar extinction coefficient 9,300 M−1 cm−1) in 100 mM of sodium tartrate (pH 3.0) at 310 nm [18]. MnP activity was measured by following the formation of Mn3+-tartrate complex (molar extinction coefficient 6,500 M−1 cm−1), buffered with 100 mM sodium tartrate (pH 4.5) in the presence of 0.4 mM MnSO4 at 238 nm [19]. Peroxidase reactions were started by the addition of 0.1 mM H2O2, and enzyme activity was expressed as units per mL (10−6 mol min−1 mL−1). Laccase activity was expressed in units defined as 1 μmol ABTS oxidized per minute per milliliter.
Determination of protein and reducing sugar concentration
The Bradford protein quantitative kit is a colorimetric method for protein concentration, which is similar to the well-documented Lowry assay [20], but with the following modifications. The reaction reached 90% of its maximum color development within 15 min. The detailed microplate assay protocol followed the manufacturer’s instructions with bovine serum albumin as the standard. The amount of samples and reagents was decreased in proportion. The reducing sugar concentration in the supernatant was measured by the 3,5-dinitrosalicylic acid (DNS) method [21].
Native polyacrylamide gel electrophoresis (Native-PAGE)
To analyze the relative composition and activity of laccase, two types of PAGE gel were employed: NativePAGETM 4–16% Bis–Tris Gels from Invitrogen Company and 10% native polyacrylamide gel prepared by us. Native-PAGE (10%) was performed under non-denaturing conditions. The separating and stacking gels contained 10 and 5% acrylamide, respectively. The buffer solution used for the separating gel contained 375 mM Tris–HCl (pH 8.8), and the stacking gel buffer contained 125 mM Tris–HCl (pH 6.8). The electrode reservoir solution contained 25 mM Tris and 192 mM glycine (pH 8.8). The crude enzyme was mixed with sample buffer in the proportion (4:1), and the buffer contained 310 mM Tris–HCl (pH 6.8), 50% (w/v) glycerol and 0.05% (w/v) bromophenol blue. As much as 30 μl of each mixed sample was deposited per lane. After pre-electrophoresis for about 30 min at 20 mA, the sample reached the dividing line and then separated at 15 °C for 1.5 h with constant intensity (40 mA). The separated laccase bands were visualized by the reaction with 1.0 mM ABTS in 0.1 M sodium tartrate buffer (pH 5.0) at room temperature.
Statistical analysis
All the experiments were done in triplicate; the average of triplicate determinations was used to represent the result. Trends were considered as significant when mean values of compared sets were different at P < 0.05.
Results and discussion
Screening of co-cultured fungi and raw substrates based on laccase production
Cereal straw is a major agricultural by-product that can be upgraded successfully by microbial treatment. Investigations on straw biodelignification mostly have implied treatments with white-rot fungi to obtain carbohydrate-enriched substrates for animal feeding, or production of sugars and ethanol by using further enzymatic transformations [22, 23]. In this study, co-cultivation of different fungi under the submerged condition was preliminarily compared by using four agricultural residue substrates. The production of laccase was evaluated at different culturing times. As in the results presented in Fig. 1a–d, laccase production was significantly enhanced by using corncob as the substrate when compared with other substrates except rice stalk, which had a higher laccase activity (>100 U/ml) than corncob. The co-cultivation of P. radiata with D. squalens or C. subvermispora showed significantly more production of laccase than their respective monocultures. Interestingly, Chen et al. [12] had a similar discovery with submerged co-cultures of the white-rot fungi for decomposing pure lignin. The improvement of laccase was greatly induced by the co-cultivation of P. radiata with D. squalens or C. subvermispora, especially for maintaining stable maximal production. On the contrary, the co-cultivation of C. subvermispora and D. squalens did not stimulate enzyme production, and this combination showed a dramatically lower laccase activity than the monoculture of D. squalens, which indicated that C. subvermispora would inhibit the expression of laccase when co-cultivated with D. squalens. Nevertheless, there was no such inhibitory effect in the co-cultured P. radiata and C. subvermispora, demonstrating that the suppression was species specific.
The selection of appropriate plant residue adequate for fungus growth and target enzymes synthesis played an important role in the development of an efficient technology of enzyme production. In this study, corncob was regarded as the suitable agricultural substrate for laccase production. Table 1 shows that the lignocellulose content of four raw agricultural substrates, which indicate lignocellulose composition, has a regulatory influence on laccase production. Lignin was a great barrier for the degradation of lignocellulose, so less lignin was helpful for the degradation. Because corncob had the least lignin (9–15%) and the most amounts of lignocellulose (88–95%), the production of laccase continued for a longer time. Besides, it was observed that at the culture time of 6 or 9 days, the enzyme activity in many cases was down compared to previous and later culture times (Fig. 2), especially in the case of high enzyme production, which might imply that fungus growth and target enzymes synthesis reached the peak at day 6 or day 9, but the lack of limited and available nutriment in the culture medium resulted in declining production of laccase in the following days. This phenomenon could also be observed in the study of Chen et al. [12]; the exact kinetic profile and the abnormal phenomenon in the case of using rice straw as the substrate would be analyzed in further research.
Comparison of various co-cultured combinations on MnP activity using different substrates
Chi et al. [11] claimed that MnP was stimulated in co-cultures of P. ostreatus with C. subvermispora or P. rivulosus. Similarly, the improved productions of MnP and LiP were observed in the co-culture of P. ostreatus and P. radiata (MnP = 800 nkat L−1 after 4 days of incubation; LiP = 60 nkat L−1 after 7 days of incubation) in the submerged culture containing 0.1% (w/v) lignin [12]. In this study, MnP was evaluated with different agricultural substrates. As presented in Fig. 2, the comparative results of MnP activity showed that corncob was beneficial for MnP expression in contrast to other raw substrates during the postponed cultivation period. Clearly, the co-cultured P. radiata and D. squalens exhibited the best production of MnP than many other fungal cultures after 9 days (Fig. 2b), whereas there was no determinate suppression or synergy phenomenon in other culture broths. Corn stalk was the most unsuitable substrate for MnP production, whether by monocultures or co-cultures. The compositions of different agricultural substrates certainly determined the utilization of lignin-containing materials and LMEs production [14]. Moreover, the highest MnP activity emerged in monoculture of D. squalens using wheat straw as the substrate after 9 days. The exact origin has not been understood, which is abnormal and needs further research.
However, LiP was not spectrometrically measured in the culture broths of the four substrates degraded by the designed fungi and co-cultured combinations, although it was found to be secreted by P. radiata [12, 30]. The expression level of LiP was probably too low to be determined, or LiP was not expressed in these cultures.
The present data verified the type of lignocellulosic substrate that appeared to determine the types and amounts of LMEs produced by the white-rot fungi; furthermore, the stimulating effect of fungal interaction on enzyme production was likely species specific. Though the exact mechanism of this stimulation has not been understood, the interspecific interaction has shown a promising strategy to efficiently improve ligninolytic enzyme production [31].
Effects of glucose concentrations on laccase and MnP production
Previous research has revealed that low nitrogen was significantly favorable for laccase production with the mixed culture of P. radiata and D. squalens, but laccase production was distinctly suppressed in the carbon-meager media under nitrogen-limitation condition, in contrast to MnP expression [12]. To determine the effect of different glucose concentrations on LMEs production by the co-cultures of all paired combinations under poor nutrition conditions, different concentrations of glucose in the nitrogen-meager medium containing corncob were designed. As shown in Fig. 3, the comparison results indicated that higher glucose concentration in the carbon- and nitrogen-meager medium was helpful for the stable and maximal production of laccase by the co-cultivated P. radiata and D. squalens, though it might have a higher laccase activity under extreme conditions. The co-cultivation of P. radiata and D. squalens was beneficial for laccase production in comparison to the single fungus (P. radiata or D. squalens) under two designed C/N culture media before 9 days. Especially, the production of laccase was highly affected by levels of nutrient carbon from the mixed culture of P. radiata and C. subvermispora, and the significant promoted laccase production appeared in higher glucose nutritional condition. The reduced laccase production in the co-cultures and monocultures after 9 days was likely due to the decreasing available carbon nutrients, and stable enzyme activity might stem from a balance of production and consumption.
Effect of different concentrations of glucose on laccase production by submerged co-cultures and monocultures. a 0.1% glucose; b 0.01% glucose. The basal medium (g/L) contained 20 corncob powder, 0.03 peptone, 0.060 KH2PO4, 0.0001 ZnSO4, 0.04 K2HPO4, 0.00005 FeSO4, 0.005 MnSO4 and 0.050 MgSO4. PR P. radiata, DS D. squalens, CS C. subvermispora
Meanwhile, MnP was also compared using two designed C/N culture media. The results presented in Fig. 4 demonstrated that MnP was greatly improved in the culture medium containing 0.1% (w/v) glucose compared to 0.01% glucose. Among the comparison of different designed fungi or co-cultures, it was clear that the co-culturing of P. radiata and D. squalens produced more MnP than other fungi or combinations. But the measured MnP of C. subvermispora with P. radiata or D. squalens showed lower activities than their monocultures, respectively, regardless of change of glucose concentration, suggesting that C. subvermispora might have an inhibitory action on MnP production when co-cultured with P. radiata and D. squalens.
Effect of different concentrations of glucose on MnP production by submerged co-cultures and monocultures. a 0.1% glucose; b 0.01% glucose. The basal medium (g/L) contained 20 corncob powder, 0.03 peptone, 0.060 KH2PO4, 0.0001 ZnSO4, 0.04 K2HPO4, 0.00005 FeSO4, 0.005 MnSO4, and 0.050 MgSO4. PR P. radiata, DS D. squalens, CS C. subvermispora
As in the enzymatic data determined above, laccase and MnP were the important enzymes produced by the co-cultured combination of P. radiata and D. squalens. However, glucose consumption remains to be understood. Table 2 shows that the reduced glucose consumption at high C/N ratio in the culture medium is faster than that at low ratio of C/N. The strain-specific effects were not observed in the two designed media. Three combinations of P. radiata, D. squalens and C. subvermispora were more sensitive to the addition of glucose in comparison to the single fungus. Mycelia growth was the first step before degrading agricultural substrates. The activity variations of laccase and MnP productions coincided with the consumption of reduced glucose, which also testified to the analysis above. Hatakka reported that white-rot fungi typically produce multiple isoforms of oxidative enzymes, which are differentially regulated by nutrient limitation [7]. High glucose contributed to fungal growth and high laccase and MnP production [32]. Therefore, after inoculation, P. radiata and D. squalens grew first, with higher glucose possibly resulting in faster fungal growth, and then larger amounts of laccase and MnP were possibly produced unless restrained by a repressor. The present results provide more evidence for understanding the regulatory mechanism of glucose concentration on LMEs production characteristics in co-cultures under starvation conditions.
Laccase characterization under different raw substrates through Native-PAGE
To verify the possible presence of laccase isoforms and their differential responses under co-culture and the monoculture conditions, Native-PAGE analyses with ABTS as the substrate were carried out. As shown in Fig. 5, Native-PAGE by NativePAGETM 4–16% Bis–Tris Gels showed a clear increment of laccase bands for the co-cultured P. radiata with D. squalens or C. subvermispora culturing in corn stalk and corncob, and the bands were also more evident than in other pure cultures. Furthermore, two different isoforms of laccase were observed in the co-culturing broth of corncob compared with the corresponding pure culture of P. radiata and D. squalens, and the production of one isozyme was improved dramatically (Fig. 6). Given the data above, it revealed different laccase production owing to the interaction between P. radiata and D. squalens. Chi et al. [11] also found the clear increment of laccase for the co-cultured groups evaluated by Western blotting strategy. As wheat straw was used as fermentation substrate, it was not observed whether the significant increment of laccase was produced by three co-cultured fungal combinations (Fig. 5d). The bands were not clearly present in the combined group of C. subvermispora and D. squalens in contrast to the respective monocultures. Though laccase produced by the co-culture of C. subvermispora and D. squalens showed the measured and visual activity (Figs. 1, 5), it was probable that low activity of laccase did not result in clear bands on PAGE at the culture time of 9 days.
Native-PAGE analysis by NativePAGETM 4–16% Bis–Tris Gels for laccase production using four raw agricultural substrates at culturing time of 9 days. a Corn stalk; b corncob; c rice stalk; d wheat straw. Cultivation medium contained (g/L) 1.0 glucose, 20 raw agricultural substrate powder, 0.03 peptone, 0.060 KH2PO4, 0.0001 ZnSO4, 0.04 K2HPO4, 0.00005 FeSO4, 0.005 MnSO4, and 0.050 MgSO4. S: standard protein markers. 1: 170 kDa; 2: 130 kDa; 3: 100 kDa; 4: 70 kDa; 5: 55 kDa; 6: 40 kDa; 7: 35 kDa. PR P. radiata, DS D. squalens, CS C. subvermispora
A 10% Native-PAGE analysis of laccase production by different co-cultured combinations and pure fungal cultures under different concentrations of glucose at the culturing time of 9 days. PGA: 0.1% glucose; PGB: 0.01% glucose; the basal medium (g/L) contained 20 corncob powder, 0.03 peptone, 0.060 KH2PO4, 0.0001 ZnSO4, 0.04 K2HPO4, 0.00005 FeSO4, 0.005 MnSO4, and 0.050 MgSO4. S: standard protein markers. 1: 170 kDa; 2: 130 kDa; 3: 100 kDa; 4: 70 kDa; 5: 55 kDa; 6: 40 kDa; 7: 35 kDa; 8: 25 kDa; 9: 15 kDa. PR P. radiata, DS D. squalens, CS C. subvermispora
Native-PAGE and enzyme activity data both revealed the presence of different molecular weight isoenzymes. The increase of enzymatic activity was attributed to an increase of constitutive and inducible enzyme levels in the combination of P. radiata with D. squalens or C. subvermispora. Some authors reported the existence of laccase isoenzymes in several white-rot fungi with molecular weights ranging from 60 to 80 kDa [33–35]. In this study, new laccase formation for P. radiata, D. squalens and C. subvermispora was found. Moreover, there were different isoforms of laccase in co-cultured P. radiata and D. squalens that differed from the respective pure culture of P. radiata or D. squalens. The production phenotype and level of laccase were both regulated by the species used during the submerged co-cultivation process.
Laccase electrophoresis characterization under different glucose concentrations
The effect of different glucose concentrations on laccase phenotype was further contrasted under nutrition-limited condition by 10% Native-PAGE. According to Fig. 6, the co-cultures of P. radiata with D. squalens or C. subvermispora exhibit the best synergistic effect on laccase production compared with the corresponding monocultures. Moreover, four bands (58, 51, 44, 40 kDa) appeared in the co-culture of P. radiata and D. squalens under different glucose concentrations, and the two laccase bands (40, 44 kDa) clearly differed from the pure culture of P. radiata or D. squalens. However, the band at 58 kDa was not clear in Fig. 6, and the band at 40 kDa was somewhat fuzzy in PGA of Fig. 6, but clear in PGB. The band at 51 kDa showed an obvious increment in the production of one isozyme. Two laccase bands observed in the co-culture of P. radiata and C. subvermispora (41 and 38 kDa) were clearly different from the monoculture of P. radiata or C. subvermispora. No obvious formation of laccase was found at the co-cultured C. subvermispora and D. squalens, though the pure culture of D. squalens formed three laccase bands at culture time of 9 days under two designed culture media, which provided more evidence for the depressing effect of C. subvermispora on laccase production with D. squalens.
Native-PAGE bands were compared between PGA and PGB (Fig. 6). Laccase production in PGA culture medium was evidently higher than in PGB. Notably, the co-culture of P. radiata with D. squalens or C. subvermispora produced more significant increment of laccase in the PGA than PGB. More interestingly, the bands of laccase in the PGA medium by the co-culturing of P. radiata and D. squalens or P. radiata and C. subvermispora were inconsistent with that of PGB. The present results herein suggested that higher concentration of glucose added under starvation conditions led to a beneficial effect on laccase production, which further confirmed the previous analysis. In summary, nutritional condition could regulate the phenotype and level of laccase production.
In the preliminary study, Native-PAGE using ABTS and guaiacol in sodium tartrate buffer as the substrate was evaluated by means of colorization, but guaiacol was not able to show clear PAGE bands, and that excess substrate would lead to excessive coloration. Modest ABTS could show clear bands of laccase, but was limited by the way in which substrate coloration occurred on Native-PAGE, in which enzymes remained alive and could be colored by the chromogenic reaction with substrates. This reaction was a dynamic process. There were several clear bands at the beginning after the addition of the substrate solution; then, the color was enhanced and thickened and more bands emerged. Finally, the thick bands became fuzzy and dispersive when almost all the bands appeared, because the laccase that were alive in the native polyacrylamide gels under non-denaturing conditions diffused. Therefore, if all required bands were to appear, waiting was essential. An increased amount of substrate should have contributed to improve resolution, but the optimum concentration was difficult to determine, probably because the difference in laccase activity was so significant that we were not able to obtain satisfactory photographs of Native-PAGE (shown in Figs. 5, 6). Though the differences were actually presented based on Native-PAGE pictures, obtaining better photographs should be considered in future research through other efficient PAGE methods.
Conclusions
Agricultural substrates containing high lignocellulose and low lignin favored laccase and MnP production. Corncob showed the most beneficial effect on laccase and MnP production with the designed fungi or combinations. The synergistic effects on LMEs production were as well observed in the co-culturing broth of P. radiata and D. squalens. Co-cultivation of P. radiata with C. subvermispora resulted in significant increase of laccase but decrease of MnP, whereas C. subvermispora showed an inhibitory effect on LMEs production with D. squalens. Native-PAGE analyses showed similar results, indicating that new isoenzymes of laccase highlighted in co-cultivation of P. radiata with D. squalens or C. subvermispora differed from their monocultures.
Abbreviations
- LMEs:
-
Lignin-modifying enzymes
- MnP:
-
Manganese peroxidases
- LiP:
-
Lignin peroxidase
- VP:
-
Versatile peroxidase
- ABTS:
-
2,2′-Azino-bis(3-ethylbenzthiazoline-6-sulfonic acid) diammonium salt
- VA:
-
Veratryl alcohol
- PR:
-
Phlebia radiata
- DS:
-
Dichomitus squalens
- CS:
-
Ceriporiopsis subvermispora
- PDA:
-
Potato dextrose agar
- DNS:
-
3,5-Dinitrosalicylic acid
- Native-PAGE:
-
Native polyacrylamide gel electrophoresis
References
Roncero MB, Torres AL, Colom JF, Vidal T (2003) TCF bleaching of wheat straw pulp using ozone and xylanase. Part A: paper quality assessment. Bioresour Technol 87:305–314
Jeffries TW (1990) Biodegradation of lignin–carbohydrate complexes. Biodegrad 1:163–176
Kersten P, Cullen D (2007) Extracellular oxidative systems of the lignin-degrading basidiomycete Phanerochaete chrysosporium. Fungal Genet Biol 44:77–87
Higuchi T (2006) Look back over the studies of lignin biochemistry. J Wood Sci 52:2–8
Geib SM, Filley TR, Hatcher PG, Hoover K, Carlson JE, Jimenez-Gasco MD, Nakagawa-Izumi A, Sleighter RL, Tien M (2008) Lignin degradation in wood-feeding insects. PNAS 105:12932–12937
Hammel KE, Cullen D (2008) Role of fungal peroxidases in biological ligninolysis. Curr Opin Plant Biol 11:349–355
Hatakka A (1994) Lignin-modifying enzymes from selected white rot fungi: production and role in lignin degradation. FEMS Microbiol Rev 13:125–135
Lundell TK, Mäkelä MR, Hildén K (2010) Lignin-modifying enzymes in filamentous basidiomycetes—ecological, functional and phylogenetic review. J Basic Microbiol 50:5–20
Belenguer A, Duncan SH, Calder AG, Holtrop G, Louis P, Lobley GE, Flint HJ (2006) Two routes of metabolic cross-feeding between Bifidobacterium adolescentis and butyrate-producing anaerobes from the human gut. Appl Environ Microbiol 72:3593–3599
Hu HL, van den Brink J, Gruben BS, Wösten HAB, Gu JD, de Vries RP (2011) Improved enzyme production by co-cultivation of Aspergillus niger and Aspergillus oryzae and with other fungi. Int Biodeterior Biodegrad 65:248–252
Chi YJ, Hatakka A, Maijala P (2007) Can co-culturing of two white-rot fungi increase lignin degradation and the production of lignin-degrading enzymes? Int Biodeterior Biodegrad 59:32–39
Chen QH, Sven K, Thomas H, Steffen R, Susanne Z (2011) Co-cultured production of lignin-modifying enzymes with white-rot fungi. Appl Biochem Biotechnol 165:700–718
Velazquez-Cedẽno MA, Farnet AM, Ferré E, Savoie JM (2004) Variations of lignocellulosic activities in dual cultures of Pleurotus ostreatus and Trichoderma longibrachiatum on unsterilized wheat straw. Mycologia 96:712–719
Zhang H, Hong YZ, Xiao YZ, Yuan J, Tu XM, Zhang XQ (2006) Efficient production of laccases by Trametes sp. AH28–2 in cocultivation with a Trichoderma strain. Appl Microbiol Biotechnol 73:89–94
Gutierrez-Correa M, Tengerdy RP (1997) Production of cellulase on sugarcane bagasse by fungal mixed culture solid substrate fermentation. Biotechnol Lett 19:665–667
Koroleva OV, Gavrilova VP, Stepanova EV, Lebedeva VI, Sverdlova NI, Landesman EO, Yavmetdinov IS, Yaropolov AI (2002) Production of lignin modifying enzymes by co-cultivated white-rot fungi Cerrena maxima and Coriolus hirsutus and characterization of laccase from Cerrena maxima. Enzym Microbiol Technol 30:573–580
Eggert C, Temp U, Eriksson KE (1996) The ligninolytic system of the white-rot fungus Pycnoporus cinnabarinus: purification and characterization of the laccase. Appl Environ Microbiol 62:1151–1158
Kirk TK, Croan S, Tien M, Murtagh KE, Farrell RE (1986) Production of multiple ligninases by Phanerochaete chrysosporium: effect of selected growth conditions and use of a mutant strain. Enzym Microbiol Technol 8:27–32
Paszczynski A, Crawford RL, Huynh VB (1988) Manganese peroxidase of Phanerochaete chrysosporium: purification. In: Wood WA, Kellogg ST (eds) Methods in Enzymology. Academic Press, New York
Lowry OH, Rosebrough NJ, Farr AL, Randall RJ (1951) Protein measurement with Folin phenol reagent. J Biol Chem 193:265–275
Miller GL (1959) Use of dinitrosalicylic acid reagent for determination of reducing sugar. Anal Chem 31:426–428
Dorado J, Almendros G, Camarero S, Martínez AT, Vares T, Hatakka A (1999) Transformation of wheat straw in the course of solid-state fermentation by four ligninolytic basidiomycetes. Enzym Microbiol Technol 25:605–612
Li A, Antizar-Ladislao B, Khraisheh M (2007) Bioconversion of municipal solid waste to glucose for bio-ethanol production. Bioprocess Biosyst Eng 30:189–196
Song C, Hu H, Zhu S, Wang G, Chen G (2004) Nonisothermal catalytic liquefaction of corn stalk in subcritical and supercritical water. Energy Fuels 18:90–96
Zhang ML, Fan YT, Xing Y, Pan CM, Zhang GS, Lay JJ (2007) Enhanced biohydrogen production from cornstalk wastes with acidification pretreatment by mixed anaerobic cultures. Biomass Bioenerg 31:250–254
Vaughan T, Seo CW, Marshall WE (2001) Removal of selected metal ions from aqueous solution using modified corncobs. Bioresour Technol 78:133–139
Howard RL, Abotsi E, Jansen van Rensburg EL, Howard S (2003) Lignocellulose biotechnology: issues of bioconversion and enzyme production. Afr J Biotechnol 2:602–619
Sanchez C (2009) Lignocellulosic residues: biodegradation and bioconversion by fungi. Biotechnol Adv 27:185–194
McKendry P (2002) Energy production from biomass (part 1): overview of biomass. Bioresour Technol 83:37–46
Vares T, Kalsi M, Hatakka A (1995) Lignin peroxidases, manganese peroxidases, and other ligninolytic enzymes produced by Phlebia radiata during solid-state fermentation of wheat straw. Appl Environ Microbiol 61:3515–3520
Elisashvili V, Kachlishvili E (2009) Physiological regulation of laccase and manganese peroxidase production by white-rot Basidiomycetes. J Biotehnol 144:37–42
Tekere M, Zvauya R, Read JS (2001) Ligninolytic enzyme production in selected sub-tropical white rot fungi under different culture conditions. J Basic Microbiol 41:115–129
Šušla M, Novotný C, Svobodová K (2007) The implication of Dichomitus squalens laccase isoenzymes in dye decolorization by immobilized fungal cultures. Bioresour Technol 98:2109–2115
Garcia TA, Santiago MF, Ulhoa CJ (2007) Studies on the Pycnoporus sanguineus CCT-4518 laccase purified by hydrophobic interaction chromatography. Appl Microbiol Biotechnol 75:311–318
Fonseca MI, Shimizu E, Zapata PD, Villalba LL (2010) Copper inducing effect on laccase production of white rot fungi native from Misiones (Argentina). Enzym Microbiol Technol 46:534–539
Acknowledgments
This study was financially supported by the Natural Science Foundation of Zhejiang Province, China (Y3090026).
Author information
Authors and Affiliations
Corresponding author
Additional information
The authors Y.-C. Dong and W. Wang contributed equally to this work.
Rights and permissions
About this article
Cite this article
Dong, YC., Wang, W., Hu, ZC. et al. The synergistic effect on production of lignin-modifying enzymes through submerged co-cultivation of Phlebia radiata, Dichomitus squalens and Ceriporiopsis subvermispora using agricultural residues. Bioprocess Biosyst Eng 35, 751–760 (2012). https://doi.org/10.1007/s00449-011-0655-3
Received:
Accepted:
Published:
Issue Date:
DOI: https://doi.org/10.1007/s00449-011-0655-3